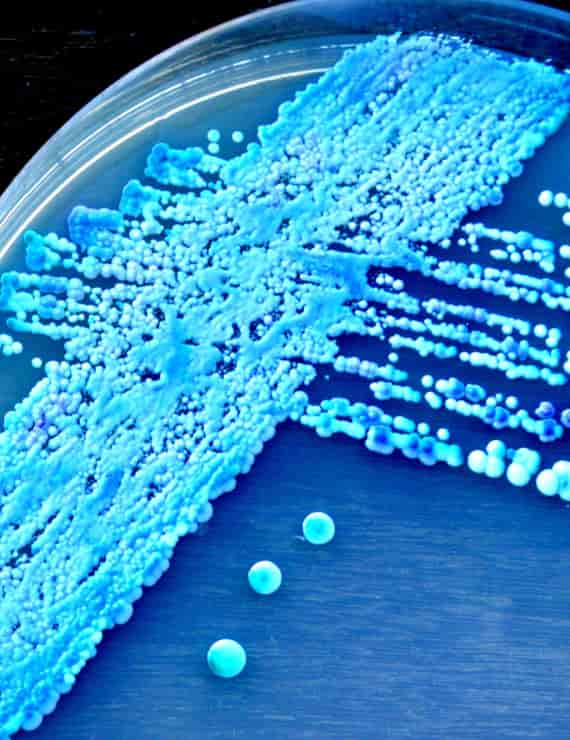
cultivo-de-levadura
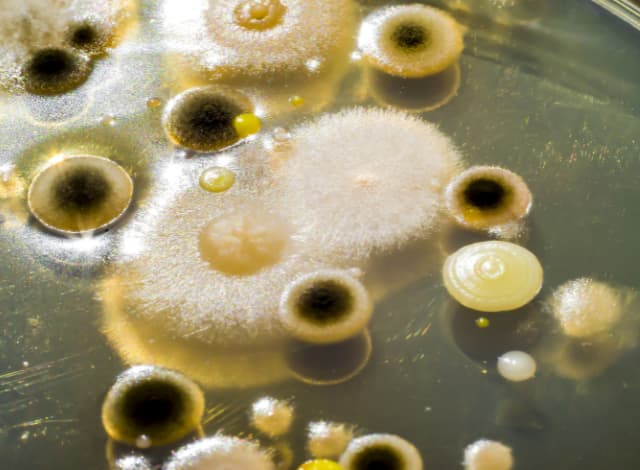
colonias-de-diferentes-bacterias-y-hongos

Proteínas y estabilidad del vino
La influencia de las proteínas en la estabilidad del vino: un aspecto todavía poco comprendido
Contenidos
A pesar de su importancia en la calidad final del vino, las proteínas continúan siendo una de las fracciones menos estudiadas y comprendidas del mosto.
Esta falta de conocimiento se debe, en gran parte, a la dificultad que implica su aislamiento dentro de una matriz tan compleja como la del vino, así como a las múltiples interacciones que las proteínas establecen con otros componentes presentes, como los polifenoles, taninos o sales minerales.

El estudio de las proteínas de la uva comenzó formalmente a finales de la década de 1950, cuando los investigadores KOCH y SAJAK (1959) lograron clasificar estas moléculas en diferentes fracciones.
Sus trabajos pioneros también demostraron que la concentración de proteínas varía significativamente según la variedad de uva, y que existe una correlación negativa entre su contenido y la estabilidad del vino durante el almacenamiento.
En las décadas siguientes, la investigación en este campo se centró principalmente en entender la composición proteica con el objetivo de mejorar la estabilidad coloidal del vino, evitar turbideces proteicas y reducir la necesidad de tratamientos agresivos que puedan afectar su calidad organoléptica.
Hoy en día, aunque se ha avanzado en la caracterización de algunas proteínas responsables de la inestabilidad, como las proteínas ricas en prolina o las glucanas, queda aún mucho por descubrir.
Profundizar en el conocimiento de estas fracciones podría abrir nuevas vías para una vinificación más precisa y respetuosa con la materia prima, reduciendo intervenciones y mejorando la calidad final del producto.
Implicaciones para el trabajo en bodega
Para los enólogos, entender el comportamiento de las proteínas en el vino no es solo una cuestión técnica, sino también estratégica.
Un manejo más afinado de estos compuestos puede traducirse en decisiones más informadas sobre clarificación, estabilización y conservación.
Además, a medida que el consumidor demanda vinos más naturales y con menos intervención, el conocimiento profundo de las proteínas y su influencia en la estabilidad permite optimizar procesos sin comprometer la autenticidad del vino.
Invertir en investigación y análisis proteico no solo mejora la calidad, también abre la puerta a una producción más sostenible y controlada.
Influencia sobre el vino
Las proteínas presentes en el vino son uno de los principales factores responsables de la aparición de turbideces, especialmente en vinos blancos, y por tanto, juegan un papel clave en su estabilidad física y visual.
Su presencia puede comprometer la claridad del producto final, generando depósitos o velos indeseados que afectan tanto la estética como la percepción de calidad por parte del consumidor.
Diversos estudios han buscado métodos eficaces para determinar el contenido de proteínas en el vino, así como caracterizarlas según parámetros como el peso molecular o el punto isoeléctrico.
Estas investigaciones también han tenido en cuenta variables como el grado de madurez de las uvas, la temperatura durante el proceso de vinificación y la capacidad de adsorción de agentes clarificantes como la bentonita, utilizada comúnmente para eliminar estas proteínas inestables.
Hasta la fecha, se han logrado detectar proteínas en diferentes tipos de vino mediante diversas técnicas analíticas. Sin embargo, los resultados obtenidos siguen siendo parciales y no del todo uniformes, lo que refleja las limitaciones actuales tanto en metodologías como en la disponibilidad de bases de datos completas.
Un avance significativo en esta línea lo aportó KWON (2004), quien llevó a cabo una de las primeras identificaciones a gran escala de proteínas en un vino blanco, específicamente en un Sauvignon Blanc.
En su estudio, identificó un total de veinte proteínas, clasificadas según su origen: cinco procedentes de la uva, doce de levaduras, dos de bacterias y una de un hongo.

KWON atribuyó el bajo número de proteínas de origen vegetal a las limitaciones en las bases de datos disponibles en ese momento, lo que pone de manifiesto la necesidad de seguir desarrollando herramientas más precisas para su identificación.
Curiosamente, hasta el momento no se ha realizado una identificación exhaustiva de las proteínas en vinos tintos, lo cual representa una oportunidad de investigación abierta.
Entender estas diferencias no solo podría aportar claridad sobre las dinámicas proteicas en distintos tipos de vino, sino también sobre cómo varían sus efectos según el perfil fenólico o las técnicas de elaboración aplicadas.
Factores que influyen en el contenido proteico de la baya de la uva y en el vino
El contenido en proteínas de la baya de la uva depende de su grado de madurez. Cuanto más madura esté la cosecha, mayor será su contenido en proteínas.
Para una proteína similar a la taumatina, una proteína de transferencia de lípidos, así como para las quitinasas.
Se ha podido demostrar que estas proteínas se acumulan simultáneamente con el azúcar durante la maduración de las uvas, lo cual es de gran importancia para la resistencia contra los patógenos.
Las proteínas de la baya de la uva que se transfieren al vino están muy influenciadas por el tipo de tratamiento del vino y, en particular, por las medidas de clarificación.

El uso de la bentonita como agente clarificador y precipitante está muy extendido, especialmente para la reducción de la turbidez de las proteínas.
Se ha demostrado que el tratamiento del vino con bentonita conduce a una reducción significativa, aunque no específica, de la concentración de proteínas.
Composición de las proteínas del vino
La principal proporción de proteínas en el vino se encuentra entre 20 y 30 kDa (kilodalton), mientras que otras proteínas se encuentran en el rango de 14 a más de 100 kDa.
Las principales proteínas identificadas en el vino son las proteínas similares a la taumatina y las quitinasas, que se asignan al grupo de proteínas PR (relacionadas con la patogénesis).
Una gran proporción de las proteínas del vino se clasifican como glicoproteínas, aunque las afirmaciones sobre la proporción de proteínas del vino glicosiladas son muy contradictorias.
Manoproteínas
El término manoproteínas se refiere a las glicoproteínas procedentes de la pared celular de las levaduras con un alto contenido en carbohidratos, caracterizado por un contenido en manosa de al menos el 95%.
Según la cepa de levadura utilizada y las condiciones de fermentación, se liberan en el vino durante la fermentación y la maduración.

En la tecnología del vino, las manoproteínas son importantes en muchos aspectos.
Por un lado, tienen un efecto negativo en los procesos de filtración por membrana debido al ensuciamiento de las membranas y, por tanto, a la reducción del caudal.
Por otro lado, tienen una serie de efectos positivos en cuanto a las propiedades tecnológicas y cualitativas.
Contribuyen a la estabilidad del vino estabilizando el ácido tartárico y reduciendo la turbidez causada por las proteínas.
Además, se discute la estabilización de la espuma en los vinos espumosos, una influencia en la estabilidad del aroma y del color, así como una mejora de la sensación en boca.
Influencia de las proteínas en la calidad del vino
Aunque las proteínas sólo están presentes en el vino en cantidades comparativamente pequeñas, tienen una influencia significativa en la calidad.
Algunas proteínas tienen efectos positivos, especialmente las manoproteínas de la levadura Saccharomyces cerevisiae, que se describió en la sección anterior.

Por otro lado, las proteínas también son responsables de fenómenos negativos como la turbidez.
Que conlleva una reducción de la calidad del producto y de la aceptación del consumidor.
La formación de turbidez o depósitos se produce principalmente en el vino embotellado durante el almacenamiento, especialmente a altas temperaturas.
Las proteínas pueden volverse insolubles o agregarse y posteriormente precipitarse y flocular.
Origen de las proteínas en el vino
Las posibles fuentes de proteínas del vino son -además de la propia uva- las levaduras, las bacterias y los hongos que liberan proteínas por autolisis durante la elaboración del vino.
Así como los posibles agentes clarificantes que contienen proteínas, como la caseína y la gelatina.
Debido a la modificación de la obligación de etiquetado de los posibles alérgenos en los alimentos, se han realizado estudios nacionales e internacionales.
Encaminados a determinar si se puede demostrar la introducción de proteínas mediante agentes clarificantes.
Un estudio reciente muestra que en la Comarca berciana, los vinos bercianos no contienen ningún residuo de los agentes clarificantes isinglass ni gelatina de pescado.
Los más usados serían la albúmina de leche o caseína, lisozima y la clara de huevo que se encuentran en cantidades muy pequeñas como residuos en el vino.


Mientras que, por un lado, las proteínas pueden ser introducidas en el vino por los microorganismos descritos, por otro lado, no todas las proteínas contenidas en la baya de la uva llegan al vino.
Algunas proteínas se vuelven insolubles y se eliminan durante los procesos de clarificación y clarificación, otras son hidrolizadas por la actividad proteolítica de las he-feteas.
Los estudios realizados con métodos inmunológicos demuestran que la mayoría de las proteínas que contiene el vino proceden de la uva.
Contenido en proteínas y factores que influyen en el contenido en proteínas del vino
Los datos sobre el contenido de proteínas en el vino varían según el tipo de vino y, en particular, según el método de determinación y el tipo de purificación en el laboratorio.
Para los vinos blancos, los contenidos de proteínas oscilan entre 0,1 y 500 mg/l .
Durante mucho tiempo se asumió que el vino tinto no contenía proteínas porque éstas se unen a los taninos liberados por la piel y las semillas durante la fermentación.
Un estudio de YOKOTSUKA ET AL lo refutó ya en 1994, aunque incluso publicaciones posteriores se adhieren a esta tesis.
El contenido de proteínas en el vino depende de la variedad de uva, así como del grado de maduración de la misma, por lo que la concentración de proteínas aumenta con la maduración.
Además, el suelo, el clima y, en gran medida, los métodos de elaboración del vino pueden influir en el contenido de proteínas y en su composición.

El prensado de uvas enteras o despalilladas, la duración del contacto con los hollejos (tiempo de maceración) y el calentamiento de la maceración.
Factores que influyen en el contenido en proteínas del vino
La adición de azufre y la adición de bentonita y otros agentes clarificantes son factores que influyen. Diferentes proteínas se ven afectadas por estos procesos en diferentes grados.
Cuando se considera el contenido de proteínas en el curso de la elaboración del vino, primero se produce una reducción del contenido de proteínas mediante la filtración y la centrifugación.
Durante la fermentación alcohólica y tras la adición de levadura, el contenido de proteínas vuelve a aumentar, para reducirse de nuevo tras el clarificado.
Tanto la cantidad como la composición de las proteínas cambian en el curso de la elaboración del vino. El contenido de proteínas se reduce a aproximadamente una quinta parte de la baya de la uva al mosto y a aproximadamente un tercio del mosto al vino.
Este descenso se debe en parte a la reducción de las concentraciones de proteínas y en parte a la eliminación completa de las mismas, por lo que se separan especialmente las proteínas con carga positiva, ya que éstas son eliminadas preferentemente por la bentonita.
Las proteínas que se encuentran en el vino terminado se caracterizan por su estabilidad a valores de pH ácidos y su resistencia a la proteólisis.
Influencia de la bentonita
La bentonita, un mineral de silicato de aluminio procesado, se utiliza desde hace varias décadas para reducir la turbidez de las proteínas y del cobre del vino.
En el vino se forma una dispersión con partículas cargadas negativamente, que adsorben principalmente las proteínas del vino cargadas positivamente con un punto isoeléctrico (pI) superior a 5,8 mediante efectos de intercambio electrostático.
A altas dosis, también se adsorben las proteínas con menor pI. Los compuestos proteínicos de la bentonita se coagulan y pueden eliminarse por golpeo, centrifugación o filtración.

Sin embargo, incluso después del tratamiento con bentonita.
Aproximadamente la mitad de las proteínas solubles permanecen en el vino, dependiendo de la variedad de uva.
La cantidad de bentonita añadida ha pasado de unos 20 g/hl a 40 g/hl, a 80 g/hl y a más de 120 g/hl en la actualidad, debido a los cambios en las técnicas de elaboración y vinificación.
En dosis elevadas (>80 g/hl), la bentonita puede perjudicar el sabor y el color, ya que además de las proteínas, se eliminan otros componentes cargados positivamente como antocianos, taninos y polisacáridos.
Proteínas relacionadas con la patogénesis
Las proteínas relacionadas con la patogénesis (proteínas PR) son producidas por la planta durante el proceso de maduración de las bayas.
La producción puede verse incrementada por el estrés, el ataque de patógenos como hongos, bacterias y virus, y por factores abióticos.

Las proteínas PR se dividen en catorce familias de proteínas no relacionadas, que tienen en común su función en el sistema de defensa de la planta.
Se caracterizan por su gran estabilidad a bajos valores de pH y su actividad proteolítica. Muchas proteínas de PR son alérgenos conocidos.
El 25 % de todas las alergias causadas por las plantas y que figuran en la base de datos oficial de alérgenos de la Unión Internacional de Sociedades de Inmunología están causadas por proteínas PR.
Proteínas similares a la taumatina
Las proteínas similares a la taumatina (TLP) reciben su nombre de la homología de la secuencia con la taumatina, una proteína de sabor intensamente dulce aislada de Thaumatococcus da- niellii Benth, una fruta de África Occidental.
Las proteínas similares a la taumatina están subordinadas a la familia PR-5. La resistencia de las proteínas similares a la taumatina a las proteasas y a la desnaturalización inducida por el pH o el calor se debe principalmente a la presencia de dieciséis cisteínas conservadas, que forman ocho puentes disulfuro.
Debido a su gran estabilidad, también sobreviven al proceso de elaboración del vino y pueden ser detectados en el producto final.
Quitinasas
Las quitinasas vegetales desempeñan un importante papel en el sistema de defensa de las plantas contra los fitopatógenos.

Se producen cada vez más tras el ataque de los hongos o el contacto con sustancias que desencadenan reacciones de defensa específicas en la planta e inhiben el crecimiento de los hongos.
Su efecto antifúngico se debe principalmente a su actividad contra la quitina, un componente estructural principal de muchas células fúngicas.
Proteínas de transferencia de lípidos
Las proteínas de transferencia de lípidos (LTP) son pequeñas proteínas básicas ampliamente distribuidas en el reino vegetal.
Desempeñan un papel importante en la defensa de las plantas contra los hongos y las bacterias y como componentes de la cutina y la suberina contra el estrés abiótico.
En las plantas, las proteínas de transferencia de lípidos se localizan en grandes cantidades, especialmente en la piel y la cáscara. Según su función, se asignan a la familia 14 de las proteínas PR.